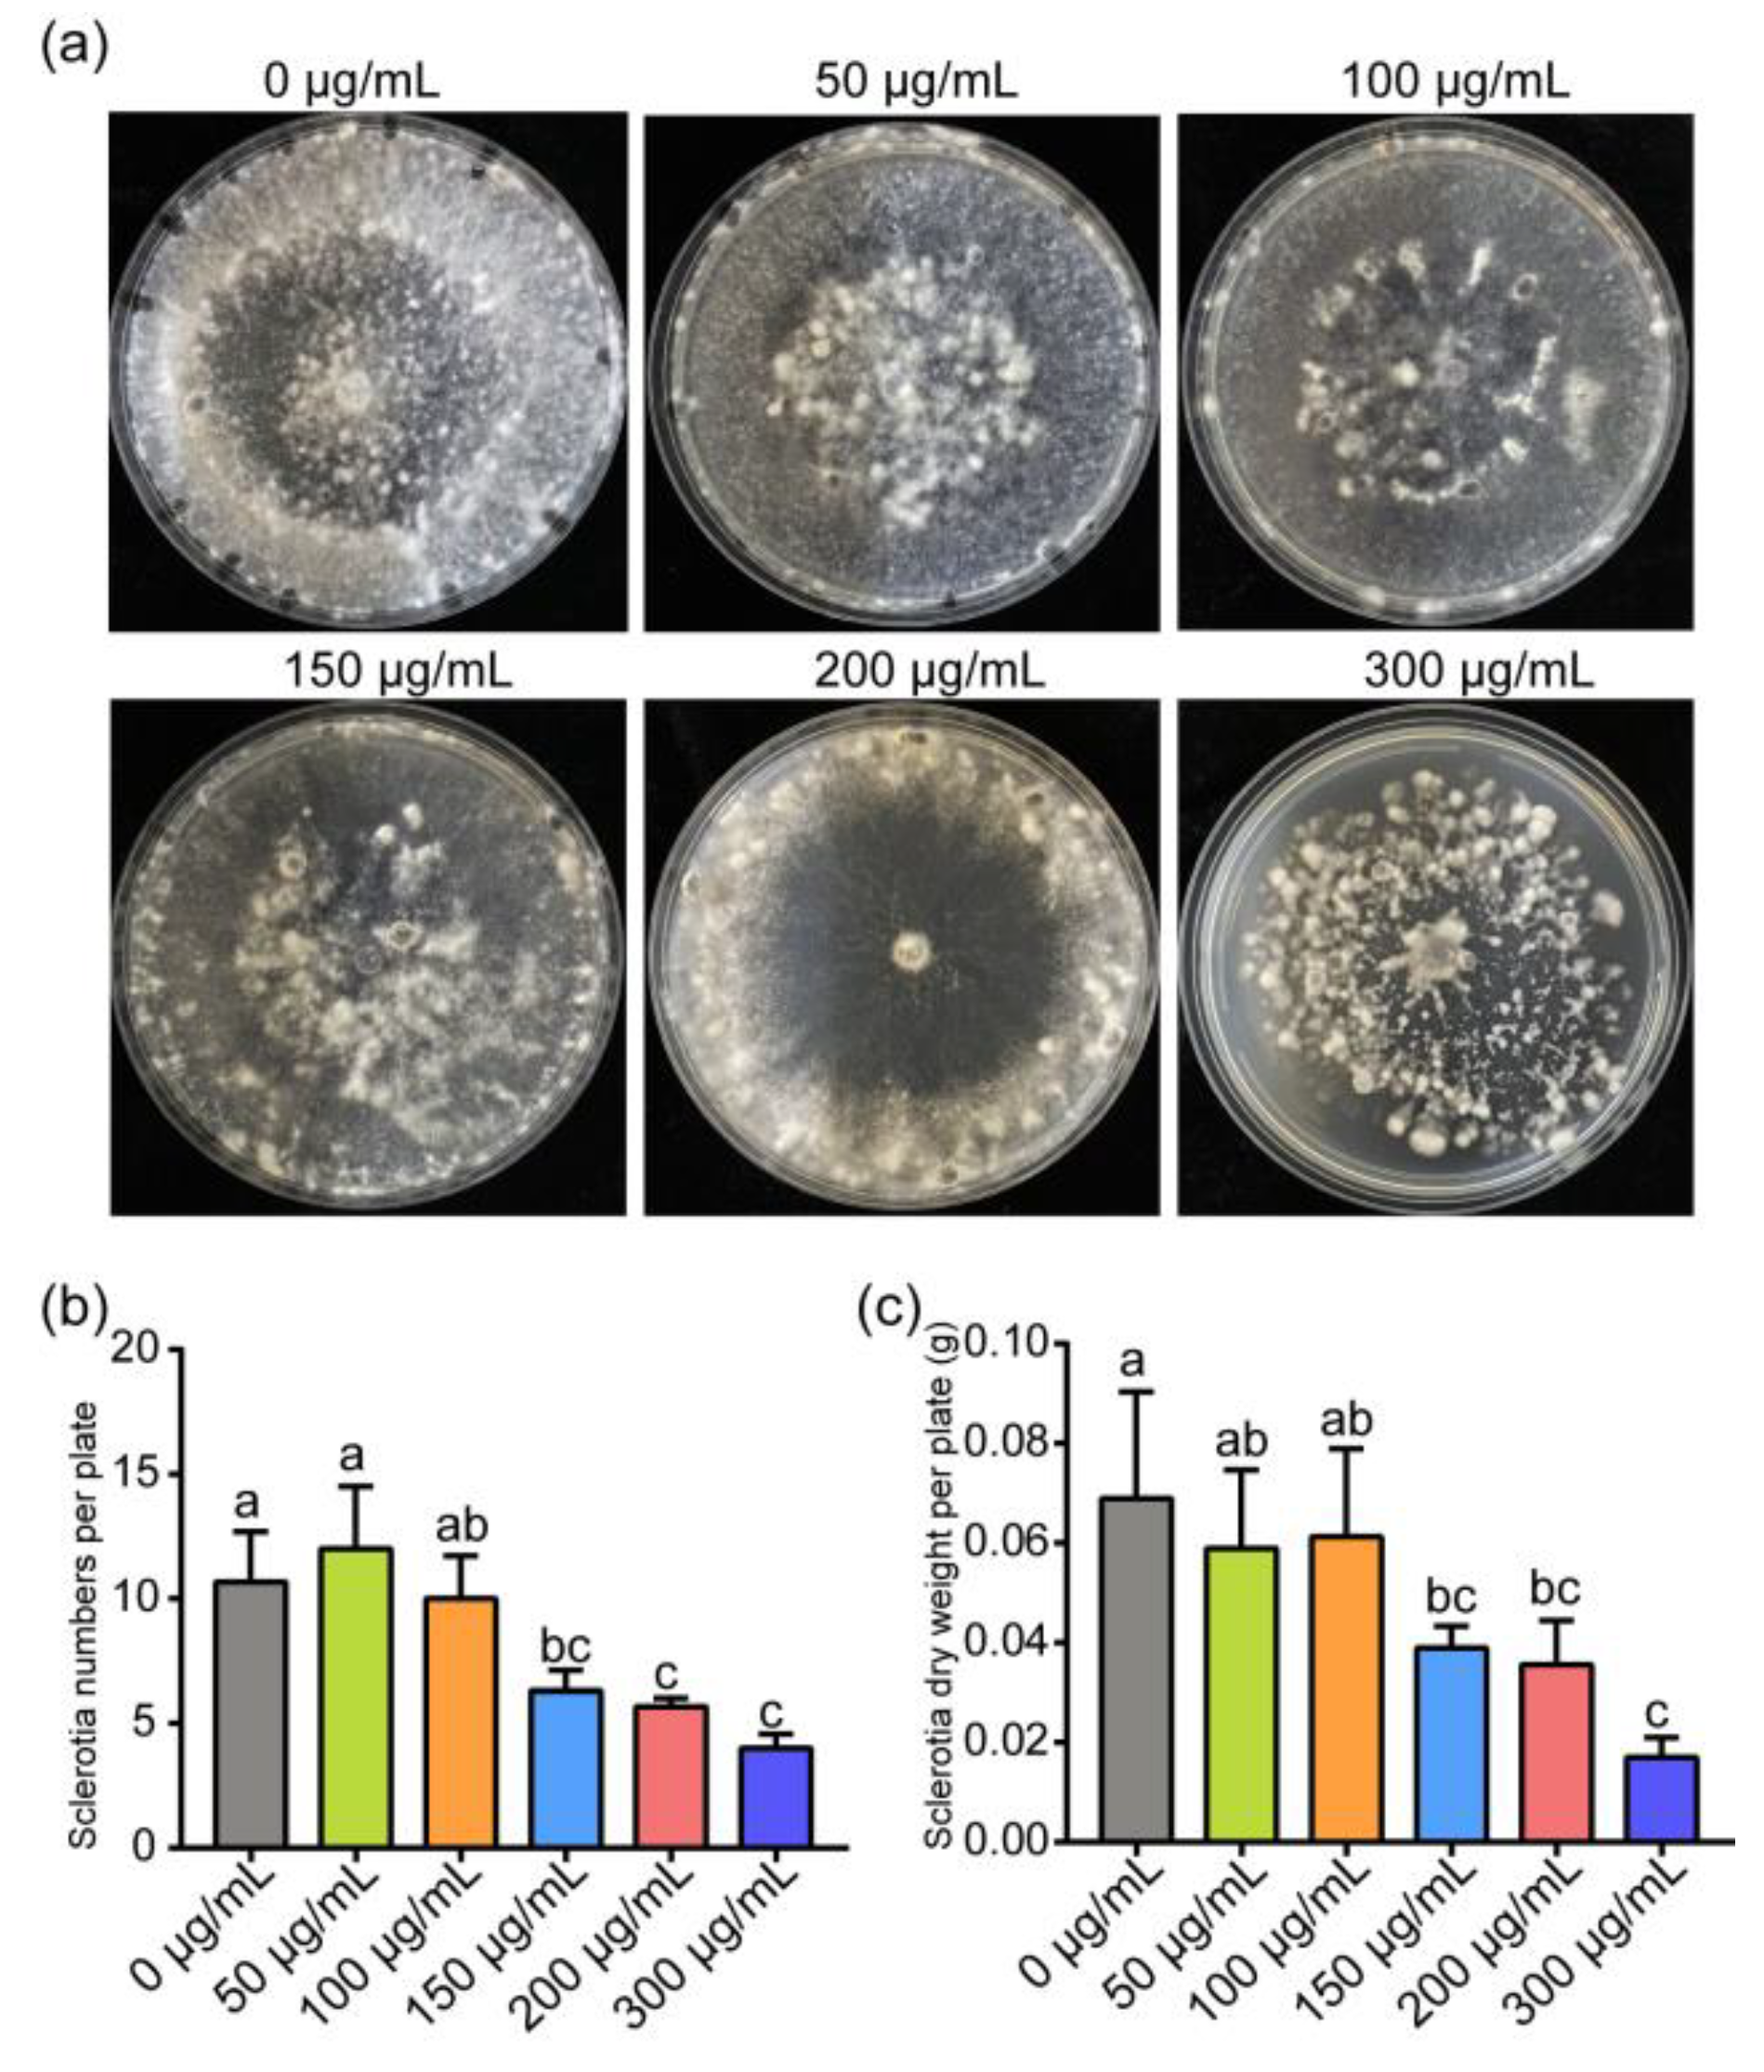
Jof 07 00821 g002 Jof 07 00821 g002

ε-poly-L-lysine Affects the Vegetative Growth, Pathogenicity and Expression Regulation of Necrotrophic Pathogen Sclerotinia sclerotiorum and Botrytis cinerea
Abstract
1. Introduction
2. Materials and Methods
2.1. Preparation of Microbial Agent ε-PL
2.2. Pathogenic Fungi and Plants
2.3. Antifungal Activity of ε-PL In Vitro
2.4. Antifungal Activity of ε-PL on Detached Leaves
2.5. cDNA Library Construction and Illumina Sequencing
2.6. Reverse-Transcription Quantitative PCR (RT-qPCR) Assay
2.7. Statistical Analysis
3. Results
3.1. ε-PL Inhibit Growth and Development of S. sclerotiorum and B. cinerea
3.2. Inhibition of ε-PL on Infection of S. sclerotiorum and B. cinerea In Vivo
3.3. Transcription Analysis of S. sclerotiorum and B. cinerea Affected by ε-PL
3.4. Gene Expression Involved in the Growth and Pathogenicity, Metabolism, Stress Responses and Detoxification
4. Discussion
Supplementary Materials
Author Contributions
Funding
Institutional Review Board Statement
Informed Consent Statement
Data Availability Statement
Conflicts of Interest
References
- van Bruggen, A.H.; Finckh, M.R. Plant diseases and management approaches in organic farming systems. Annu. Rev. Phytopathol. 2016, 54, 25–54. [Google Scholar] [CrossRef]
- Liang, X.; Rollins, J.A. Mechanisms of broad host range necrotrophic pathogenesis in Sclerotinia sclerotiorum. Phytopathology 2018, 108, 1128–1140. [Google Scholar] [CrossRef]
- Xu, L.; Li, G.; Jiang, D.; Chen, W. Sclerotinia sclerotiorum: An evaluation of virulence theories. Annu. Rev. Phytopathol. 2018, 56, 311–338. [Google Scholar] [CrossRef]
- Boland, G.J.; Hall, R. Index of plant hosts of Sclerotinia sclerotiorum. Can. J. Plant. Pathol. 1994, 16, 93–108. [Google Scholar] [CrossRef]
- Bolton, M.D.; Thomma, B.P.; Nelson, B.D. Sclerotinia sclerotiorum (Lib.) de Bary: Biology and molecular traits of a cosmopolitan pathogen. Mol. Plant. Pathol. 2006, 7, 1–16. [Google Scholar] [CrossRef]
- Tian, J.; Chen, C.; Sun, H.; Wang, Z.; Steinkellner, S.; Feng, J.; Liang, Y. Proteomic analysis reveals the importance of exudates on sclerotial development in Sclerotinia sclerotiorum. J. Agric. Food Chem. 2021, 69, 1430–1440. [Google Scholar] [CrossRef]
- Billon-Grand, G.; Rascle, C.; Droux, M.; Rollins, J.A.; Poussereau, N. pH modulation differs during sunflower cotyledon colonization by the two closely related necrotrophic fungi Botrytis cinerea and Sclerotinia sclerotiorum. Mol. Plant. Pathol. 2012, 13, 568–578. [Google Scholar] [CrossRef] [PubMed]
- Amselem, J.; Cuomo, C.A.; van Kan, J.A.; Viaud, M.; Benito, E.P.; Couloux, A.; Coutinho, P.M.; de Vries, R.P.; Dyer, P.S.; Fillinger, S.; et al. Genomic analysis of the necrotrophic fungal pathogens Sclerotinia sclerotiorum and Botrytis cinerea. PLoS Genet. 2011, 7, e1002230. [Google Scholar] [CrossRef] [PubMed]
- De Simone, N.; Pace, B. Botrytis cinerea and table grapes: A review of the main physical, chemical, and Bio-based control treatments in post-harvest. Foods 2020, 9, 1138. [Google Scholar] [CrossRef] [PubMed]
- Jiao, W.; Li, X.; Wang, X.; Cao, J.; Jiang, W. Chlorogenic acid induces resistance against Penicillium expansum in peach fruit by activating the salicylic acid signaling pathway. Food Chem. 2018, 260, 274–282. [Google Scholar] [CrossRef]
- Forté, C.A.; Colacino, J.; Polemi, K.; Guytingco, A.; Peraino, N.J.; Jindaphong, S.; Kaviya, T.; Westrick, J.; Neitzel, R.; Nambunmee, K. Pesticide exposure and adverse health effects associated with farmwork in Northern Thailand. J. Occup. Health 2021, 63, e12222. [Google Scholar] [CrossRef] [PubMed]
- Peng, Y.; Li, S.J.; Yan, J.; Tang, Y.; Cheng, J.P.; Gao, A.J.; Yao, X.; Ruan, J.J.; Xu, B.L. Research progress on phytopathogenic fungi and their role as biocontrol agents. Front. Microbiol. 2021, 12, 670135. [Google Scholar] [CrossRef] [PubMed]
- Li, S.; Yang, B.; Tan, G.Y.; Ouyang, L.M.; Qiu, S.; Wang, W.; Xiang, W.; Zhang, L. Polyketide pesticides from actinomycetes. Curr. Opin. Biotech. 2021, 69, 299–307. [Google Scholar] [CrossRef]
- Quinn, G.A.; Banat, A.M.; Abdelhameed, A.M.; Banat, I.M. Streptomyces from traditional medicine: Sources of new innovations in antibiotic discovery. J. Med. Microbiol. 2020, 69, 1040–1048. [Google Scholar] [CrossRef] [PubMed]
- Shima, S.; Sakai, H. Polylysine produced by Streptomyces. Agric. Biol. Chem. 1977, 41, 1807–1809. [Google Scholar] [CrossRef]
- Li, S.; Tang, L.; Chen, X.; Liao, L.; Li, F.; Mao, Z. Isolation and characterization of a novel epsilon-poly-L-lysine producing strain: Streptomyces griseofuscus. J. Ind. Microbiol. Biot. 2011, 38, 557–563. [Google Scholar] [CrossRef]
- Li, Y.; Han, Q.; Feng, J.; Tian, W.; Mo, H. Antibacterial characteristics and mechanisms of ɛ-poly-lysine against Escherichia coli and Staphylococcus aureus. Food Control. 2014, 43, 22–27. [Google Scholar] [CrossRef]
- Hamano, Y. Occurrence, biosynthesis, biodegradation, and industrial and medical applications of a naturally occurring epsilon-poly-L-lysine. Biosci. Biotech. Bioch. 2011, 75, 1226–1233. [Google Scholar] [CrossRef]
- Delihas, N.; Riley, L.W.; Loo, W.; Berkowitz, J.; Poltoratskaia, N. High-sensitivity of mycobacterium species to the bactericidal activity by polylysine. FEMS Microbiol. Lett. 1995, 132, 233–237. [Google Scholar] [CrossRef][Green Version]
- Shima, S.; Matsuoka, H.; Iwamoto, T.; Sakai, H. Antimicrobial action of epsilon-poly-L-lysine. J. Antibiot. 1984, 37, 1449–1455. [Google Scholar] [CrossRef]
- Liu, H.; Chen, J.; Xia, Z.; An, M.; Wu, Y. Effects of ε-poly-l-lysine on vegetative growth, pathogenicity and gene expression of Alternaria alternata infecting Nicotiana tabacum. Pestic. Biochem. Physiol. 2020, 163, 147–153. [Google Scholar] [CrossRef]
- Liu, K.; Zhou, X.; Fu, M. Inhibiting effects of epsilon-poly-lysine (ε-PL) on Pencillium digitatum and its involved mechanism. Postharvest Biol. Technol. 2017, 123, 94–101. [Google Scholar] [CrossRef]
- Jiao, W.; Liu, X.; Chen, Q.; Du, Y.; Li, Y.; Yue, F.; Dong, X.; Fu, M. Epsilon-poly-L-lysine (ε-PL) exhibits antifungal activity in vivo and in vitro against Botrytis cinerea and mechanism involved. Postharvest Biol. Technol. 2020, 168, 111270. [Google Scholar] [CrossRef]
- Chen, J.; Liu, H.; Xia, Z.; Zhao, X.; Wu, Y.; An, M. Purification and structural analysis of the effective anti-TMV compound “ε-Poly-L-lysine produced by Streptomyces ahygroscopicus. Molecules 2019, 24, 1156. [Google Scholar] [CrossRef] [PubMed]
- Liu, H.; Zhao, X.; Yu, M.; Meng, L.; Zhou, T.; Shan, Y.; Liu, X.; Xia, Z.; An, M.; Wu, Y. Transcriptomic and functional analyses indicate novel anti-viral mode of actions on tobacco mosaic virus of a microbial natural product ε-Poly-L-lysine. J. Agric. Food Chem. 2021, 69, 2076–2086. [Google Scholar] [CrossRef] [PubMed]
- Sun, G.; Yang, Q.; Zhang, A.; Guo, J.; Liu, X.; Wang, Y.; Ma, Q. Synergistic effect of the combined bio-fungicides ε-poly-l-lysine and chitooligosaccharide in controlling gray mould (Botrytis cinerea) in tomatoes. Int. J. Food Microbiol. 2018, 276, 46–53. [Google Scholar] [CrossRef]
- Shen, T.; Wang, Q.; Li, C.; Zhou, B.; Li, Y.; Liu, Y. Transcriptome sequencing analysis reveals silver nanoparticles antifungal molecular mechanism of the soil fungi Fusarium solani species complex. J. Hazard. Mater. 2020, 388, 122063. [Google Scholar] [CrossRef]
- Yang, X.; Zhang, L.; Xiang, Y.; Du, L.; Huang, X.; Liu, Y. Comparative transcriptome analysis of Sclerotinia sclerotiorum revealed its response mechanisms to the biological control agent, Bacillus amyloliquefaciens. Sci. Rep. 2020, 10, 12576. [Google Scholar] [CrossRef]
- Liang, Y.; Xiong, W.; Steinkellner, S.; Feng, J. Deficiency of the melanin biosynthesis genes SCD1 and THR1 affects sclerotial development and vegetative growth, but not pathogenicity, in Sclerotinia sclerotiorum. Mol. Plant. Pathol. 2018, 19, 1444–1453. [Google Scholar] [CrossRef]
- An, M.; Tong, Z.; Ding, C.; Wang, Z.; Sun, H.; Xia, Z.; Qi, M.; Wu, Y.; Liang, Y. Molecular characterization of the thaumatin-like protein PR-NP24 in tomato fruits. J. Agric. Food Chem. 2019, 67, 13001–13009. [Google Scholar] [CrossRef]
- Sun, H.; Tian, J.; Steinkellner, S.; Liang, Y. Identification and characterization of Colletotrichum destructivum causing anthracnose on sunflower. Arch. Microbiol. 2020, 202, 1459–1467. [Google Scholar] [CrossRef]
- Li, J.T.; Mu, W.H.; Veluchamy, S.; Liu, Y.Z.; Zhang, Y.H.; Pan, H.Y.; Rollins, J.A. The GATA-type IVb zinc-finger transcription factor SsNsd1 regulates asexual–sexual development and appressoria formation in Sclerotinia sclerotiorum. Mol. Plant. Pathol. 2018, 19, 1679–1689. [Google Scholar] [CrossRef]
- Sun, G.Z.; Wang, H.; Shi, B.B.; Shangguan, N.N.; Wang, Y.; Ma, Q. Control efficiency and expressions of resistance genes in tomato plants treated with ε-poly-L-lysine against Botrytis cinerea. Pestic. Biochem. Physiol. 2017, 143, 191–198. [Google Scholar] [CrossRef]
- Chubukov, V.; Gerosa, L.; Kochanowski, K.; Sauer, U. Coordination of microbial metabolism. Nat. Rev. Microbiol. 2014, 12, 327–340. [Google Scholar] [CrossRef]
- Westrick, N.M.; Ranjan, A.; Jain, S.; Grau, C.R.; Smith, D.L.; Kabbage, M. Gene regulation of Sclerotinia sclerotiorum during infection of Glycine max: On the road to pathogenesis. BMC Genom. 2019, 20, 157. [Google Scholar] [CrossRef]
- Xie, F.; Murray, J.D.; Kim, J.; Heckmann, A.B.; Edwards, A.; Oldroyd, G.E.; Downie, J.A. Legume pectate lyase required for root infection by rhizobia. Proc. Natl. Acad. Sci. USA 2012, 109, 633–638. [Google Scholar] [CrossRef] [PubMed]
- Li, F.; Ma, F.; Zhao, H.; Zhang, S.; Wang, L.; Zhang, X.; Yu, H. A lytic polysaccharide monooxygenase from a white-rot fungus drives the degradation of lignin by a versatile peroxidase. Appl. Environ. Microb. 2019, 85, e02803-18. [Google Scholar] [CrossRef] [PubMed]
- Kumar, P.; Satyanarayana, T. Microbial glucoamylases: Characteristics and applications. Crit. Rev. Biotechnol. 2009, 29, 225–255. [Google Scholar] [CrossRef] [PubMed]
- Takagi, K.; Kikkawa, A.; Iwama, R.; Fukuda, R.; Horiuchi, H. Type II phosphatidylserine decarboxylase is crucial for the growth and morphogenesis of the filamentous fungus Aspergillus nidulans. J. Biosci. Bioeng. 2021, 131, 139–146. [Google Scholar] [CrossRef]
- Deng, C.; Saunders, W.S. RIM4 encodes a meiotic activator required for early events of meiosis in Saccharomyces cerevisiae. Mol. Genet. Genom. 2001, 266, 497–504. [Google Scholar] [CrossRef]
- Bhatt, K.; Lal, S.; Srinivasan, R.; Joshi, B. Molecular analysis of Bacillus velezensis KB 2216, purification and biochemical characterization of alpha-amylase. Int. J. Biol. Macromol. 2020, 164, 3332–3339. [Google Scholar] [CrossRef]
- Amobonye, A.; Singh, S.; Pillai, S. Recent advances in microbial glutaminase production and applications-a concise review. Crit. Rev. Biotechnol. 2019, 39, 944–963. [Google Scholar] [CrossRef] [PubMed]
- Bühlmann, M.; Walrad, P.; Rico, E.; Ivens, A.; Capewell, P.; Naguleswaran, A.; Roditi, I.; Matthews, K.R. NMD3 regulates both mRNA and rRNA nuclear export in African trypanosomes via an XPOI-linked pathway. Nucleic Acids Res. 2015, 43, 4491–4504. [Google Scholar] [CrossRef] [PubMed]
- Dallal Bashi, Z.; Rimmer, S.R.; Khachatourians, G.G.; Hegedus, D.D. Factors governing the regulation of Sclerotinia sclerotiorum cutinase A and polygalacturonase 1 during different stages of infection. Can. J. Microbiol. 2012, 58, 605–616. [Google Scholar] [CrossRef] [PubMed]
- Muszewska, A.; Stepniewska-Dziubinska, M.M.; Steczkiewicz, K.; Pawlowska, J.; Dziedzic, A.; Ginalski, K. Fungal lifestyle reflected in serine protease repertoire. Sci. Rep. 2017, 7, 9147. [Google Scholar] [CrossRef] [PubMed]
- Dalmais, B.; Schumacher, J.; Moraga, J.; Pêcheur, P.L.E.; Tudzynski, B.; Collado, I.G.; Viaud, M. The Botrytis cinerea phytotoxin botcinic acid requires two polyketide synthases for production and has a redundant role in virulence with botrydial. Mol. Plant. Pathol. 2011, 12, 564–579. [Google Scholar] [CrossRef]
- Sales, K.; Brandt, W.; Rumbak, E.; Lindsey, G. The LEA-like protein HSP 12 in Saccharomyces cerevisiae has a plasma membrane location and protects membranes against desiccation and ethanol-induced stress. Biochim. Biophys. Acta 2000, 1463, 267–278. [Google Scholar] [CrossRef]
- Alfonso-Prieto, M.; Biarnés, X.; Vidossich, P.; Rovira, C. The molecular mechanism of the catalase reaction. J. Am. Chem. Soc. 2009, 131, 11751–11761. [Google Scholar] [CrossRef] [PubMed]
- Sang, H.; Hulvey, J.P.; Green, R.; Xu, H.; Im, J.; Chang, T.; Jung, G. A xenobiotic detoxification pathway through transcriptional regulation in filamentous fungi. mBio 2018, 9, e00457-18. [Google Scholar] [CrossRef]
- Vela-Corcía, D.; Aditya Srivastava, D.; Dafa-Berger, A.; Rotem, N.; Barda, O.; Levy, M. MFS transporter from Botrytis cinerea provides tolerance to glucosinolate-breakdown products and is required for pathogenicity. Nat. Commun. 2019, 10, 2886. [Google Scholar] [CrossRef]
- Moreno, A.; Banerjee, A.; Prasad, R.; Falson, P. PDR-like ABC systems in pathogenic fungi. Res. Microbiol. 2019, 170, 417–425. [Google Scholar] [CrossRef]
- Barski, O.A.; Tipparaju, S.M.; Bhatnagar, A. The aldo-keto reductase superfamily and its role in drug metabolism and detoxification. Drug Metab. Rev. 2008, 40, 553–624. [Google Scholar] [CrossRef]
- Miura, D.; Sugiyama, K.; Ito, A.; Ohba-Tanaka, A.; Tanaka, M.; Shintani, T.; Gomi, K. The PDR-type ABC transporters AtrA and AtrG are involved in azole drug resistance in Aspergillus oryzae. Biosci. Biotech. Bioch. 2018, 82, 1840–1848. [Google Scholar] [CrossRef]
- Ajay, K.P.; Awanish, K. Improved microbial biosynthesis strategies and multifarious applications of the natural biopolymer epsilon-poly-L-lysine. Process. Biochem. 2014, 49, 496–505. [Google Scholar]
- Shu, C.; Cui, K.B.; Li, Q.Q.; Cao, J.K.; Jiang, W.B. Epsilon-poly-l-lysine (ε-PL) exhibits multifaceted antifungal mechanisms of action that control postharvest Alternaria rot. Int. J. Food Microbiol. 2021, 348, 109224. [Google Scholar] [CrossRef]
- Purev, E.; Kondo, T.; Takemoto, D.; Niones, J.T.; Ojika, M. Identification of ε-Poly-L-lysine as an antimicrobial product from an epichloë endophyte and isolation of fungal ε-PL synthetase gene. Molecules 2020, 25, 1032. [Google Scholar] [CrossRef]
- Wang, X.; Gong, C.; Zhao, Y.; Shen, L. Transcriptome and resistance-related genes analysis of Botrytis cinerea B05.10 strain to different selective pressures of cyprodinil and fenhexamid. Front. Microbiol. 2018, 9, 2591. [Google Scholar] [CrossRef] [PubMed]
- Reboledo, G.; Agorio, A.; Vignale, L.; Batista-García, R.A.; Ponce De León, I. Botrytis cinerea transcriptome during the infection process of the Bryophyte Physcomitrium patens and angiosperms. J. Fungi. 2020, 7, 11. [Google Scholar] [CrossRef] [PubMed]
- Sun, X.; Liu, D.; Wang, Y.; Ma, A. Biogenesis of macrofungal sclerotia: Influencing factors and molecular mechanisms. Appl. Microbiol. Biot. 2020, 104, 4227–4234. [Google Scholar] [CrossRef]
- Kubicek, C.P.; Starr, T.L.; Glass, N.L. Plant cell wall-degrading enzymes and their secretion in plant-pathogenic fungi. Annu. Rev. Phytopathol. 2014, 52, 427–451. [Google Scholar] [CrossRef] [PubMed]
- Oliveira, M.B.; Barbosa, S.C.; Petrofeza, S. Comparative in vitro and in planta analyses of extracellular enzymes secreted by the pathogenic fungus Sclerotinia sclerotiorum. Genet. Mol. Res. 2013, 12, 1796–1807. [Google Scholar] [CrossRef] [PubMed]
- Cutler, H.G.; Parker, S.R.; Ross, S.A.; Crumley, F.G.; Schreiner, P.R. Homobotcinolide: A biologically active natural homolog of botcinolide from Botrytis cinerea. Biosci. Biotech. Bioch. 1996, 60, 656–658. [Google Scholar] [CrossRef] [PubMed]
- Liu, L.; Wang, Q.; Sun, Y.; Zhang, Y.; Zhang, X.; Liu, J.; Yu, G.; Pan, H. Sssfh1, a gene encoding a putative component of the RSC chromatin remodeling complex, is involved in hyphal growth, reactive oxygen species accumulation, and pathogenicity in Sclerotinia sclerotiorum. Front. Microbiol. 2018, 9, 1828. [Google Scholar] [CrossRef] [PubMed]
- Mousavi, S.A.A.; Robson, G.D. Oxidative and amphotericin B-mediated cell death in the opportunistic pathogen Aspergillus fumigatus is associated with an apoptotic-like phenotype. Microbiology 2004, 150, 1937–1945. [Google Scholar] [CrossRef] [PubMed]
- Richter, K.; Haslbeck, M.; Buchner, J. The heat shock response: Life on the verge of death. Mol. Cell 2010, 40, 253–266. [Google Scholar] [CrossRef] [PubMed]
- Vanden Bossche, H.; Koymans, L. Cytochromes P450 in fungi. Mycoses 1998, 41, 32–38. [Google Scholar] [CrossRef] [PubMed]

| Gene Category | Gene Description | log2FC | Regulate | Gene Functions | References |
|---|---|---|---|---|---|
| Fungus growth and metabolism | |||||
| SS1G_09392 | glucoamylase | 1.42 | up | starch metabolism | [38] |
| SS1G_04563 | phosphatidylserine decarboxylase | −2.51 | down | growth and morphogenesis | [39] |
| SS1G_03997 | meiotic activator RIM4 | −1.54 | down | required for meiosis | [40] |
| SS1G_13472 | alpha-amylase A amy3 | −0.68 | down | starch metabolism | [41] |
| SS1G_08889 | glutaminase A | −1.65 | down | glutamic acid synthesis | [42] |
| BC1G_10486 | glutaminase A | −1.11 | down | glutamic acid synthesis | [42] |
| BC1G_03554 | ribosomal export protein NMD3 | 1.02 | up | mRNA and rRNA export | [43] |
| Pathogenisis | |||||
| SS1G_06037 | glucan 1,3-beta-glucosidase | −0.75 | down | cell wall degradation | [36] |
| SS1G_09216 | glucan 1,3-beta-glucosidase EXG1 | −1.05 | down | pectin degradation | [36] |
| SS1G_13386 | cutinase A | −2.11 | down | cuticle degradation | [44] |
| SS1G_09821 | polysaccharide monooxygenase | 1.47 | up | lignin or cellulose degradation | [37] |
| SS1G_12413 | serine carboxypeptidase | −1.03 | down | virulence determinants | [45] |
| BC1G_13346 | probable beta-glucosidase I | −1.31 | down | cell wall degradation | [36] |
| BC1G_02936 | cutinase A | −1.47 | down | plant cuticle degradation | [44] |
| BC1G_09000 | probable pectate lyase | −1.08 | down | cell wall degradation | [36] |
| BCIN_01g00010 | oxidoreductase BOA1 | −2.77 | down | putative botcinic acid synthesis | [46] |
| BC1G_16083 | FAD-binding monooxygenase BOA2 | −2.81 | down | putative botcinic acid synthesis | [46] |
| Stress response | |||||
| SS1G_05007 | 12 kDa heat shock protein | 1.91 | up | stress response | [47] |
| SS1G_05200 | catalase A (catA) | 0.88 | up | stress response | [48] |
| BC1G_14178 | heat shock protein 16 | 1.35 | up | stress response | |
| BC1G_12146 | catalase 7 (cat 7) | 1.42 | up | stress response | [48] |
| Detoxification | |||||
| SS1G_00119 | cytochrome P450 monooxygenase lepH | 1.24 | up | metabolizing enzymes | [49] |
| SS1G_00121 | cytochrome P450 monooxygenase psiH | 0.91 | up | metabolizing enzymes | [49] |
| SS1G_11948 | MFS-type transporter SPBC409.08 | 1.77 | up | efflux transport | [50] |
| SS1G_02254 | ABC transporter ARB | 0.84 | up | efflux transport | [51] |
| SS1G_04757 | ABC transporter BEA3 | 4.59 | up | efflux transport | [51] |
| SS1G_00727 | aldo-keto reductase yakc | 3.02 | up | detoxification | [52] |
| BC1G_13302 | cytochrome P450 monooxygenase AN1598 | 1.73 | up | metabolizing enzymes | [49] |
| BC1G_13299 | glutathione S-transferase like protein tpcF | 1.33 | up | conjugating enzymes | [49] |
| BC1G_00798 | MFS-type transporter astH | 1.23 | up | efflux transport | [50] |
| BC1G_05984 | ABC multidrug transporter atrI | 1.81 | up | efflux transport | [53] |
| BC1G_02800 | ABC multidrug transporter atrA | 1.44 | up | efflux transport | [53] |
Publisher’s Note: MDPI stays neutral with regard to jurisdictional claims in published maps and institutional affiliations. |
© 2021 by the authors. Licensee MDPI, Basel, Switzerland. This article is an open access article distributed under the terms and conditions of the Creative Commons Attribution (CC BY) license (https://creativecommons.org/licenses/by/4.0/).
Share and Cite
Zhou, T.; Liu, H.; Huang, Y.; Wang, Z.; Shan, Y.; Yue, Y.; Xia, Z.; Liang, Y.; An, M.; Wu, Y. ε-poly-L-lysine Affects the Vegetative Growth, Pathogenicity and Expression Regulation of Necrotrophic Pathogen Sclerotinia sclerotiorum and Botrytis cinerea. J. Fungi 2021, 7, 821. https://doi.org/10.3390/jof7100821
Zhou T, Liu H, Huang Y, Wang Z, Shan Y, Yue Y, Xia Z, Liang Y, An M, Wu Y. ε-poly-L-lysine Affects the Vegetative Growth, Pathogenicity and Expression Regulation of Necrotrophic Pathogen Sclerotinia sclerotiorum and Botrytis cinerea. Journal of Fungi. 2021; 7(10):821. https://doi.org/10.3390/jof7100821
Chicago/Turabian StyleZhou, Tao, He Liu, Yuanmin Huang, Zehao Wang, Yuhang Shan, Yan Yue, Zihao Xia, Yue Liang, Mengnan An, and Yuanhua Wu. 2021. "ε-poly-L-lysine Affects the Vegetative Growth, Pathogenicity and Expression Regulation of Necrotrophic Pathogen Sclerotinia sclerotiorum and Botrytis cinerea" Journal of Fungi 7, no. 10: 821. https://doi.org/10.3390/jof7100821
APA StyleZhou, T., Liu, H., Huang, Y., Wang, Z., Shan, Y., Yue, Y., Xia, Z., Liang, Y., An, M., & Wu, Y. (2021). ε-poly-L-lysine Affects the Vegetative Growth, Pathogenicity and Expression Regulation of Necrotrophic Pathogen Sclerotinia sclerotiorum and Botrytis cinerea. Journal of Fungi, 7(10), 821. https://doi.org/10.3390/jof7100821

